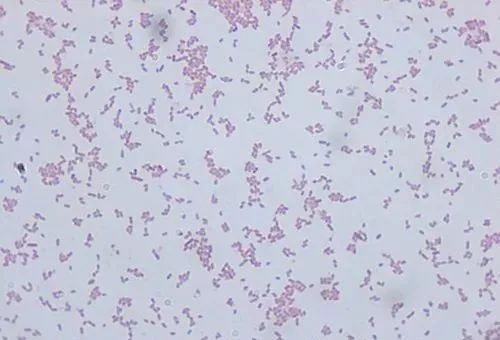
花白鲢鱼败血症怎么防治,花白鲢败血病用什么药

花白鲢是一种很好的经济鱼类,随着饲料价格的上涨,吃食性鱼类的价格徘徊不前,由于花白鲢是滤食性鱼类,有水就有鱼,除了能够净化水质外,池塘养殖效益的好坏,有一部分是由花白鲢的产量决定的。平时人们嫌弃白鲢价值低而弃养,忽略了净水的特殊功能,白鲢放养比例恰当,蓝藻暴发和水质恶化的概率就很小甚至无,并且除了苗种成本外,基本上是纯收入,照此而论应该还算是利润最高的鱼。

暴发性出血病,又称为败血症,还可称为出血性腹水病、细菌性出血病。该病是目前我国水产养殖史上危害鱼类种类最多、范围最广、季节最长、造成损失最大的一种主要传染病。最近几年来,花白鲢出血病也具有明显的上升态势,治疗难度也越来越大。尤其是进入七八月份的高温季节后,发生率高,死亡率大,损失较为惨重。花白鲢出血病在实际生产过程中因内服给药不便操作,主要是靠外用泼洒药物来控制病情,给治疗带来一定的难度。

一.流行情况及发病特点
白鲢发病率高于花鲢,每年春季3~5月份及秋季8~10月份为流行季节,以秋季8~9月份最流行;发病特点为急性、暴发性、大批量的死鱼,如不及时采取治疗措施,发病3~5天内,死亡率80%~90%,甚至可达100%。
当水质恶劣变化,pH值低于6.5时极易引起暴发流行,也就是说偏酸水体是易发的根源之一。

(头部充血)
二.病原
花白鲢出血病的病原物比较复杂,往往是寄生虫、出血病毒和细菌复合感染的结果,以细菌感染的居多。

中华鳋(鳃蛆病)
寄生虫造成鱼体创伤加快了病毒和细菌的入侵,同时也是病毒和细菌潜伏和栖息的场所,是致病的外因,最常见的寄生虫为中华鳋、指环虫和三代虫等。
(嗜水气单胞菌)
常见的致病细菌有:
①嗜水气单胞菌。每年3---11月易流行,病鱼主要表现为全身出血。
②弧菌感染。主要为弧菌科的致病菌株感染,每年5---9月易流行,病鱼主要表现为局部出血。
③ 鲁氏耶尔森氏菌 。每年3---4月易流行,病鱼主要表现为局部出血和春季死亡。

三.症状
病鱼群体常出现"暗浮头"现象。发病初期,鱼常浮于水面下10厘米左右缓慢游动,对人影反应灵敏,病情严重时则反应迟钝或无反应,表现木纳呆傻,多昼夜浮头,有时白天在太阳照射下也不下沉。

(花鲢鳃盖与下颌部充血)
外观检查:
刚死或即将死亡的鲢鱼,鳃盖外表粗糙无粘膜,鳃盖内膜有血丝,颌下部有条状或散点状红斑,嘴唇外突呈紫色,臀鳍基部发红,尾鳍有白边无粘液,严重的有蛀鳍。剪去鳃盖骨,可见鳃片红肿,粘液增多,鳃丝乌紫分瓣呈木梳齿状分离,表面有一层蓝白色光膜。网状鳃耙布满红色血点,严重的呈灰白色并腐蚀成缺刻。
解剖病鱼腹部,可见胆囊、肝、肾颜色变淡,肿大易碎;肠道内无食物,但充满粘液;肛门膨大红肿。

(左:下颌与鳃盖充血,右:口腔充血)
镜检:
鳃丝外部粘附一层白色的薄膜,有时有波峰状孢子群出现,鳃小片末端红肿,有血窦,压破后有大量单体微孢子虫出现。腹腔内大量积水,且有溶血现象。

四. 死亡症状
花白鲢出血病死亡症状比较复杂,为了便于分类治疗,有人总结归纳于以下四种类型:

1.白鲢、鲫鱼出血综合症
白鲢眼球突出鼓胀,死亡后陷入眼眶,头部和胸鳍出血明显,鲫鱼体色发黑,鳃盖和鳍条出血明显,尾鳍末端发白,解剖可见肝肾肿大,脾淤血呈紫黑色,胆棕褐色,胆汁清淡,肠道发炎有积水,大小规格均死亡,白鲢死亡严重,鲫鱼零星死亡。

2.寄生性花白鲢出血症
花白鲢头部浮肿鼓胀,鳃丝发红糜烂,镜检可见寄生虫,头部和鳍条出血明显,解剖可见肝呈粉红色,水肿,有腹水肠水,大规格苗种死亡占大多数,花白鲢闹水严重,水面常形成许多不规则的浪花。

3.病毒性花白鲢出血症
花白鲢鳃丝淤血或苍白,眼球、鳃盖、鳍条、口腔、鳞片、皮肤、肌肉均出血,解剖可见肝、肾、脾、肠、鳔等出血,但不糜烂,大小苗种均死亡,一般白鲢死亡量大于花鲢。

4.细菌性花白鲢出血症
花白鲢头部及躯干鼓胀发胖,体色发白,胸鳍和鳃盖出血,体表无其它异常现象,解剖可见肝肾胆肿大,肠道无食但有淡黄色胶状物,水面看不到病鱼漫游,鱼体肥壮,但每天有死亡。

五.预防措施
1.捕完鱼后彻底清整消毒,清除过多的淤泥并进行冻池(冬天)或曝晒(夏天)。
2.在3~4月份,可用生灰石25~40克/立方米(即30~50斤/亩)进行全池泼洒,因为偏酸水体是易发的根源之一。
3.平时消毒预防,可用二溴海因、二氧化氯等消毒剂消毒,用量均为0.3~0.4克/立方米。
4.苗种下塘(库)时,选择体质健壮、规格整齐的苗种放养。下塘前用2%~3%的食盐水或15~20克/立方米的高锰酸钾药浴10~15分钟。
5.由于鲢鱼暴发性出血病常与寄生虫病一起发生,因而在每年4月底以前,还可用硫酸铜0.5~0.7克/立方米全池泼洒或硫酸铜0.5克/立方米加0.5克/立方米晶体敌百虫进行泼洒。

六.治疗方法
1.用市售暴血平(或暴血停)等及止血因子类药物进行全池泼洒。病情严重时,上午施用止血因子类药物后,可在下午再用硫酸铜0.5~0.7克/立方米全池泼洒,以加强疗效。泼洒洒硫酸铜后,一定要注意观察鱼的活动,防止缺氧。
2.每亩用漂*粉白**1.5克/立方米、食盐1.5克/立方米、尿素0.75克/立方米、敌百虫0.6克/立方米四合剂混合溶化后全池泼洒,3天内2次。
3.每亩用二溴海因0.25~0.30克/立方米连续泼洒2天,病情较重时可间隔2天后,再用0.3克/立方米超碘季胺盐泼洒1次。
4.条件允许时,花白鲢本身就在投喂粉料的,可以用粉料拌服清热解毒、止血消炎的药物(如三黄散)进行投喂。
5.由水质不良引起的发病,用底改颗粒投施池中,并用水质改良剂等全池泼洒。
6.使用暴发病专用药,比如"花白鲢暴发止"等。

7.分类治疗:白鲢、鲫鱼出血综合症:
第一天:1米水深可用0.4%阿维菌素溶液20-25毫升/亩+硫酸亚铁150克/亩混合化水遍洒。
第二天:50%的三氯异氰脲酸片剂全池干撒,一米水深用200-300克/亩。
8.分类治疗:寄生性花白鲢出血症:
方法一,1米水深用40%辛硫磷溶液20毫升/亩+45%苯扎溴铵溶液25毫升/亩,混合化水遍洒。
方法二,40%辛硫磷溶液20毫升/亩+硫酸铜250克/亩混合化水遍洒。
方法三,0.4%伊维菌素溶液25-30毫升/亩+硫酸亚铁150克/亩混合化水遍洒。
9.分类治疗:病毒性花白鲢出血症:
①45%二元二氧化氯200克/亩+10%络合铜溶液300毫升/亩,分别溶解(使用方法见说明书),然后混合化水遍洒。
②喂粉料的花白鲢池塘可药饵内服,按5%的日饵率计算,每100千克饲料用三黄散、10%氟苯尼考、Vc、Vk各200克、100克,连喂3-5天。
10.分类治疗:细菌性花白鲢出血症:
①1米水深用20%戊二醛溶液25毫升/亩+10%季铵盐络合碘溶液150毫升/亩混合化水遍洒。
②喂花白鲢粉料的池塘可混合内服,按5%的日饵率计算,10%恩若沙星、Vc或Ve、肝胆利康散(水产用),每100千克饲料分别用300克,200克、200克,连喂3-5天。

七.败血症(出血病)常用外用药物
除了上述药物施治外,以下介绍的是治疗花白鲢乃至所有鱼类患发败血症及 出血病的主要药品种类。用量请遵从使用说明。
1.辛硫磷溶液
辛硫磷又名倍腈松,是一种农用有机磷类杀虫药。疗效独特,现在仍是治疗花白鲢乃至所有鱼类败血症及出血病的主要药品。

该药具有用量低、疗效确切、成本低廉等优点。常用处方为:
①辛硫磷溶液+硫酸铜(或有机铜)一起泼洒,这是最普遍的一种治疗措施。
②第一天泼洒辛硫磷溶液,第二天再泼洒二氧化氯。
③单独使用辛硫磷溶液一次,主要用于大水面、山塘等很少用药水面。
2.苯扎溴铵溶液
苯扎溴铵,别名新洁尔灭、溴苄烷铵,为一种季胺盐阳离子表面活性广谱杀菌剂,能迅速渗入细胞,改变细菌细胞膜通透性,影响细菌新陈代谢,导致细胞内物质流失,灭活菌体或虫体内多种酶系统,从而达到杀灭病原菌的目的。

该剂具有杀菌作用强而快、毒性低、对皮肤和组织无刺激性、渗透力强等特点。目前很多渔药企业生产含量为45%的苯扎溴铵溶液,商品名通常为“暴血灵”、“特效止血灵”、“克暴安”之类,顾名思义,该类产品是治疗出血病的专用产品,是市场上用来治疗出血病的第二大产品。
苯扎溴铵大多是通过添加特殊止血因子来保证疗效的。苯扎溴铵溶液治疗出血病的用法用量大多为每亩水深1米用30毫升,每日1次,连用2~3次。
3.二氧化氯
二氧化氯具有杀菌能力强,改善水体 环境,阴雨天也能使用等优点,实践也显示二氧化氯对治疗出血病方面表现出显著的效果。

4.二硫氰基甲烷溶液
二硫氰基甲烷是一种高效、广谱的水质改良剂,对养殖水体中的细菌、真菌、有害藻类及原生动物等都有良好抑制和改良作用。其作用时间长,适应的PH值和温度范围广,并能降低水体中的BOD、COD及氨氮、亚硝酸盐含量。实践证明其治疗花白鲢乃至所有鱼类败血症及出血病有独特效果。

此外,溴氯海因、强氯精、戊二醛等消毒剂也可用来治疗出血病,但不及前几种普遍。

八. 因高温引起中暑的花白鲢出血病
由于花白鲢是上层鱼类,如果长期处于高温天气,上层水在白天可以达到30多度,长期生活在高水温的水体中,花白鲢容易发生中暑 不适。加上早晚温差大,上层水早晚温差变化比较大,也容易引起花白鲢中暑感冒。由中暑原因引起的花白鲢出血病,一般池塘只死花白鲢,而其他鱼类正常,水质指标也正常,大多治疗效果甚微。
针对上列情况,白天多开增氧机,加强上下水体对流,打破水中隔热层,利用搅和底层低温水来降低表层水温。高温季节尽量把水加满加深,让鱼可以在底层水域"避暑"。用机器抽取地下凉水或加灌水库底漏浸水入池降温。

用药治疗中暑时,除了上述治疗和方法外,条件具备(比如花白鲢本身就在投喂粉料)的,可以加喂清热解暑的药物(比如十滴水等)。每100公斤鱼体鱼用十滴水20—40毫升,与饲料拌合,调匀后做成药饵投喂。解暑药十滴水以及藿香正气水全池遍洒正处于摸索之中。
鱼类暴发性败血症及出血病均可参照本文内容施治,仅供参考。

END
来源:水花鱼。如果发现有侵害您的利益或有不当,请及时联系我们删除。
投稿
中国水产门户网,志创渔业信息第一品牌;运营十余载,用心感悟行业发展的点滴;水产人,就上中国水产门户网。
官方微信 公众账号“scttwx”现诚征原创文章,欢迎广大行业人士踊跃投稿,积极爆料。一经采用,必有稿酬!
投稿邮箱:bbwfish@163.com
目前500000+人已关注加入我们














